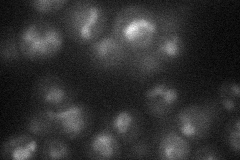
YPR003C
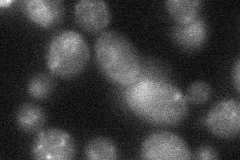
YPR003C

View description
Putative sulfate permease; physically interacts with Hsp82p; green fluorescent protein (GFP)-fusion protein localizes to the ER; YPR003C is not an essential gene
Localization:
Intensity:
Fold change:
Significance:
-
C’ GFP library in SD

below threshold19.95 -
N' NOP1pr-GFP in SD

vacuole membrane41.904 -
N' TEF2pr-mCherry in SD
vacuole16.4495 -
N' NATIVEpr-GFP in SD

missing0 -
N' TEF2pr-VC and Cyto-VN in SD
below threshold28.3207 -
C’ GFP library in SD+DTT

cytosol20.041No -
C’ GFP library in SD+H2O2

cytosol19.040.95No -
C’ GFP library in Starvation Media

cytosol25.011.25No -
C’ GFP library on the background of Pup2-DaMP

below threshold -
C’ GFP library on the background of CCT mutant

below threshold16.05690.804291No
